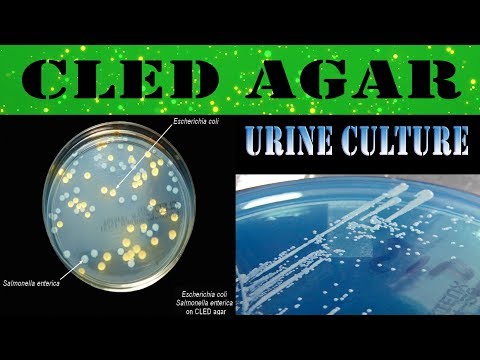

Cled }}- Hey friends I'm medical laboratory scientist.This video is about CLED agar media - urine culture/What & Why (clear explanation) - What is CLED agar? - Why use ...
Before downloading Cled Videos , Watch Free Movies Online and Stream Everything on Any Device. HD Streaming of New Full Length Movies and more. Simple and Easy.
Cled Free Download Mp4 :
Movies trailers songs reviews news CLED Agar Media - Urine Culture/What & Why (clear Explanation) | Cled
CLED agar media - urine culture/What & Why (clear explanation) - Cled - Hey friends I'm medical laboratory scientist.This video is about CLED agar media - urine culture/What & Why (clear explanation) - What is CLED agar? - Why use ...
Movies trailers songs reviews news What Is CLED Agar Media ? | Cled
What is CLED Agar Media ? - Cled - Hello Viewers !!! My Name Is Kavindu Lakmal , Medical Laboratory Science Student From University Of Peradeniya. I designed this video from my Text books ...
Movies trailers songs reviews news CLED | Cled
Movies trailers songs reviews news Sony NAB 2017: Pro Monitor & CLED | Cled
Sony NAB 2017: Pro Monitor & CLED - Cled - Gary Mandle, Senior Product Manager, takes us into the Sony NAB 2017 booth and shows the latest info about Sony's Pro Monitors and CLED display.
Movies trailers songs reviews news CLED Agar With Typical Colony Of Bacteria | Cled
CLED agar with typical colony of bacteria - Cled - CLED agar|| Typical colony of Proteus species Staphylococcus aureus.
Above is the search result of Cled Have you ever needed a fast and reliable YouTube to mp3 converter to download videos and favourite tracks, Ever tried to find an easy alternative way to get [ Convert and Download MP3 files from YouTube in few seconds or less with our reliable and free YouTube MP3 converter. Simply try our online music CLED agar with typical colony of bacteria, Cled &] a popular free mp3 download and online music player. Find free music with the search engine and listen to it while you do it
Post a Comment
Post a Comment